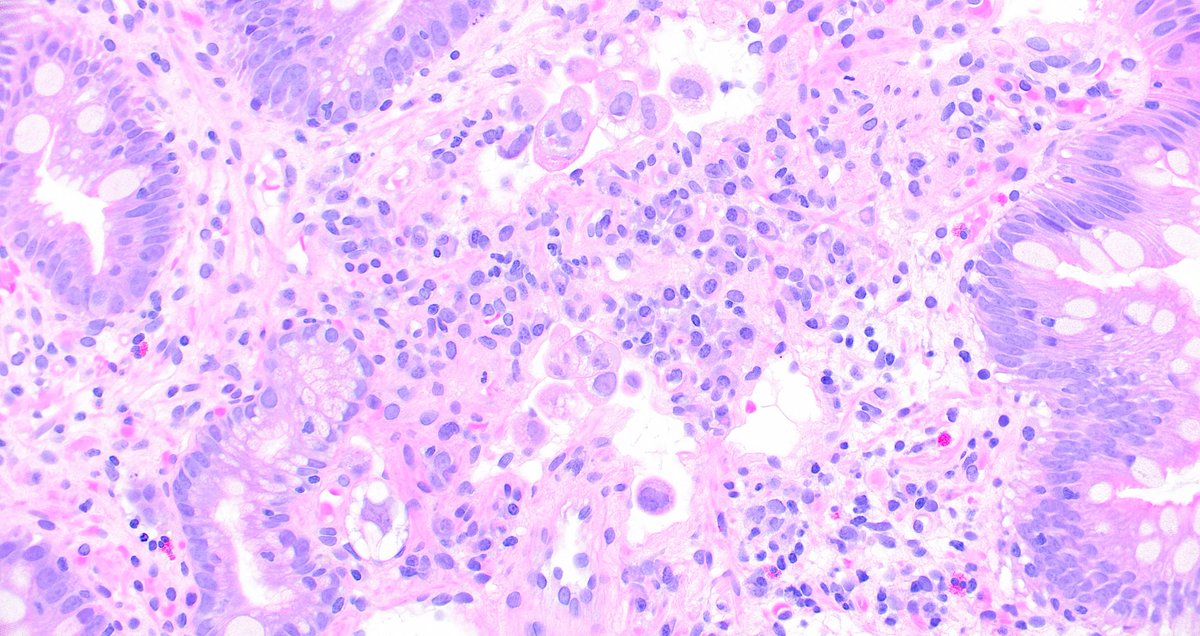
Duodenal biopsy with carcinoma in dilated lymphatics. It can be sneaky! Photos by <a href="/JBirkness/">Jackie Birkness-Gartman</a> #PathTwitter #pathology #GIpath

Jackie Birkness-Gartman
@jbirkness
Assistant Professor of Pathology at Johns Hopkins
ID: 1551360390721785856
25-07-2022 00:15:35
24 Tweet
86 Takipçi
26 Takip Edilen


Duodenal biopsy with carcinoma in dilated lymphatics. It can be sneaky! Photos by Jackie Birkness-Gartman #PathTwitter #pathology #GIpath

Granular cell tumor, presenting as esophageal nodules. Case from Jackie Birkness-Gartman #PathTwitter #pathology #GIPath



Check it out #pathtwitter: New & improved Need to Know Pathology course is now live! oakstone.com/need-to-know-p… Comes with board pass guarantee. All star roster of lecturers. Lectures now in short format, for today's kids. Don't miss out! Kevan Salimian, MD, PhD Jackie Birkness-Gartman Oakstone Publishing


Congratulations to Jackie Birkness-Gartman John Gross, MD and colleagues for making the cover of Histopathology! onlinelibrary.wiley.com/doi/10.1111/hi…



Immune microenvironment of intimal sarcomas: Adaptive immune resistance with potential therapeutic implications By Jackie Birkness-Gartman @Voltaggiol and colleagues academic.oup.com/ajcp/advance-a…





Context is everything! Radiation-associated epithelial atypia can be treacherous 😱! Learn the latest from Jackie Birkness-Gartman (PMID: 36495943) and other incredible expert pathologists at our 25th Annual Johns Hopkins GI/Liver Pathology CME Course (virtual!) hopkinscme.cloud-cme.com/course/courseo…




